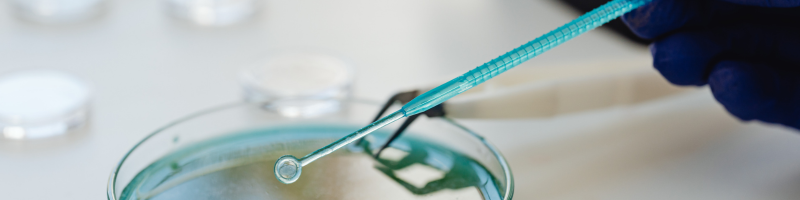
Quais são as causas Quais são as causas

Dor latejante, inchaço que parece crescer de um dia para o outro, vermelhidão e sensação de calor no local. Muitas vezes começa como algo pequeno, quase imperceptível, mas rapidamente se transforma em um problema que incomoda e muito.
O nome disso pode ser abscesso. Apesar de ser comum, ele não deve ser ignorado.
Neste texto, você vai entender o que é um abscesso, quais são os sintomas, por que ele surge, os principais tipos e como é feito o tratamento.

O que é um abscesso?
O abscesso é uma acumulação de pus em alguma parte do corpo, causada por uma infecção.
Ele acontece quando o organismo identifica a presença de bactérias, fungos ou outros agentes invasores e envia células de defesa para combatê-los. Como resultado dessa “batalha”, forma-se o pus, uma mistura de células de defesa, bactérias mortas e tecido inflamado.
Essa coleção de pus fica “encapsulada”, criando uma espécie de bolsa inflamada que pode surgir na pele ou em regiões mais profundas do corpo.
Quais são os sintomas?
Os sinais podem variar de acordo com a localização, mas os sintomas mais comuns incluem:
-
Inchaço localizado
-
Dor intensa ou latejante
-
Vermelhidão
-
Sensação de calor na área
-
Presença de pus
-
Febre (em alguns casos)
-
Mal-estar geral
Quando o abscesso é interno, os sintomas podem ser mais difíceis de identificar e incluem dor localizada profunda, febre persistente e fraqueza.
Quais são as causas?
Na maioria das vezes, o abscesso é causado por uma infecção bacteriana, especialmente pela bactéria Staphylococcus aureus. Ele pode surgir quando há algum tipo de lesão ou abertura na pele que funcione como porta de entrada para micro-organismos, como em casos de ferimentos, cortes ou arranhões. Pelos encravados e espinhas inflamadas também podem evoluir para um quadro infeccioso, assim como problemas dentários não tratados.
Além disso, complicações após procedimentos cirúrgicos e situações em que o sistema imunológico está enfraquecido aumentam o risco de desenvolvimento do abscesso. Sempre que existe uma “porta de entrada” para bactérias ou outros agentes infecciosos, as chances de formação desse acúmulo de pus se tornam maiores.
Tipos de abscesso
Existem diferentes tipos de abscesso, dependendo da região afetada.
1. Cutâneo (na pele)
É o mais comum. Surge como um caroço dolorido, avermelhado e cheio de pus. Pode aparecer em qualquer parte do corpo.
2. Dentário
Acontece na raiz do dente ou na gengiva, geralmente por cárie profunda ou infecção.
Sintomas comuns incluem dor intensa, inchaço no rosto e sensibilidade ao mastigar.
3. Perianal
Surge próximo ao ânus e costuma causar dor intensa ao sentar ou evacuar.
4. Internos
Podem ocorrer em órgãos como fígado, pulmões ou cérebro. São mais graves e exigem diagnóstico por exames de imagem.

Ele pode estourar sozinho?
Em alguns casos, o abscesso pode drenar espontaneamente. Porém, não é recomendado espremer ou tentar estourar em casa, pois isso pode espalhar a infecção para áreas mais profundas ou para a corrente sanguínea.
A manipulação inadequada pode causar complicações sérias.
Como é feito o tratamento?
O tratamento do abscesso depende do tamanho, da localização e da gravidade da infecção. Na maioria dos casos, é necessário que um profissional de saúde realize uma pequena incisão para drenar o pus acumulado, o que alivia a dor e acelera a recuperação. Em algumas situações, especialmente quando há risco de a infecção se espalhar ou quando o abscesso é mais profundo, o uso de antibióticos pode ser indicado.
Nos estágios iniciais, compressas mornas podem ajudar a aliviar o desconforto e favorecer a drenagem natural, mas não substituem a avaliação médica. Quando o abscesso é interno, pode ser necessário realizar procedimento cirúrgico ou drenagem guiada por exames de imagem, garantindo um tratamento seguro e eficaz.

Atenção aos sinais do seu corpo
O abscesso é uma resposta do organismo a uma infecção, mas isso não significa que deva ser ignorado. Embora muitas vezes pareça algo simples, ele pode evoluir e causar complicações se não for tratado corretamente.
Dor, inchaço e vermelhidão persistentes são sinais de que seu corpo está pedindo atenção.
Cuidar cedo é sempre o melhor caminho.
Leia também este texto com informações e curiosidades relacionadas à área da saúde – Soluço: quais as causas e como funciona o tratamento
